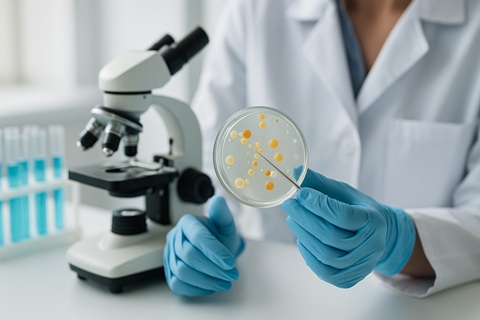
La biotech EG 427 réunit 27 M€ pour ses
avancées en médecine génomique

Jeudi 20 Février 2025 à 10h00
La biotech EG 427 réunit 27 M€ pour ses avancées en médecine génomique
Le fonds spécialisé SCI Ventures, soutenu par les principales fondations dédiées aux blessés médullaires, ainsi que des investisseurs historiques, ont également participé à ce tour de table.
Les fonds levés permettront de financer l’étude de phase 1b/2a de EG110A, notamment l’évaluation de son profil de sécurité et des premiers résultats d'efficacité.
Cette étude ouvre la voie au développement clinique dans plusieurs indications à fort besoin médical en neuro-urologie.
Le financement soutiendra également le pipeline préclinique de la société, basé sur sa plateforme technologique propriétaire de vecteurs, HERMES.
EG 427, une société de biotechnologie leader dans le développement de médecine génomique de précision pour les maladies chroniques prévalentes en neurologie, annonce aujourd'hui la clôture d’un tour de financement de série B de 27 millions d’euros, mené conjointement par Andera Partners et Bpifrance, dans le cadre de sa stratégie d'investissement InnoBio.
« La réussite de cette levée de fonds constitue une étape décisive pour EG 427, qui bénéficie du soutien de deux investisseurs institutionnels majeurs, Andera Partners et Bpifrance, ainsi que de la participation du fonds spécialisé SCI Ventures et du soutien continu de nos investisseurs historiques. Notre approche de médecine génomique peut répondre à des besoins médicaux majeurs, touchant de larges populations de patients atteints de maladies chroniques sévères. Nous nous concentrons en premier lieu sur les pathologies en neuro-urologie, pour lesquelles il existe peu d’innovations récentes, et dont l’impact financier est majeur pour les systèmes de santé. Ce tour de table nous permet de faire progresser notre étude clinique en cours pour notre premier programme ciblant les dysfonctions de la vessie, telles que la vessie neurogène. Celle-ci fournira des données essentielles sur la sécurité du produit et potentiellement les premiers signes d’efficacité », déclare Philippe Chambon, MD, PhD, Président et Directeur Général d'EG 427.
« En tant que leader mondial dans le développement des vecteurs non-réplicatifs HSV en neurologie, EG 427 a le potentiel de faire progresser considérablement l’utilisation de la médecine génomique grâce à l’extrême précision de ces vecteurs et leur administration locale. De plus, la plateforme d'EG 427 pourrait permettre des administrations répétées et une production à des coûts plus abordables comparés aux vecteurs AAV. En cas de succès, cette approche pourrait offrir une solution thérapeutique durable aux patients souffrant de maladies neurologiques chroniques », ajoute Benoît Barteau, Directeur d'Investissement chez Bpifrance – fonds InnoBio.
« La technologie d'EG 427 a le potentiel de bouleverser profondément les modalités actuelles de traitement. Le premier programme, EG110A, pourrait considérablement améliorer les options thérapeutiques dans un large panel d'indications en neuro-urologie, actuellement insuffisamment prises en charge. Nous sommes ravis d’avoir co-mené ce tour de table pour faire avancer EG110A en clinique et soutenir le développement plus large de la plateforme de médecine génomique d’EG 427 », déclare Raphaël Wisniewski, Associé chez Andera Partners.
Les fonds levés seront utilisés pour financer le développement d’EG110A en phase 1b/2a pour le traitement de l’hyperactivité du détrusor d’origine neurogène (NDO) chez les patients atteints de blessure médullaire (SCI). Cette étude menée aux États-Unis pourrait ouvrir la voie au développement clinique dans plusieurs indications à fort besoin médical en neuro-urologie, qui affectent des millions de patients.
Ce financement soutiendra également le développement du pipeline d’EG 427 constitué de plusieurs vecteurs thérapeutiques basés sur sa technologie exclusive HERpes Modular Expression System (HERMES). Dans les maladies ciblées, cette technologie offre la capacité de maintenir une activité à long terme et d'assurer un coût de production réduit, apportant ainsi un bénéfice médical et économique significatif aux systèmes de santé.
MTS Health Partners a été le conseil financier exclusif d'EG 427 lors de ce tour de table.
A propos de EG110A :
EG110A est une thérapie génique utilisant un vecteur HSV-1 non réplicatif, qui a été conçue pour inhiber de manière sélective l’activité des principaux neurones sensoriels de la vessie qui sont responsables de l'hyperactivité du muscle vésical, tout en préservant la fonction de miction. L'hyperactivité vésicale neurogène est un dysfonctionnement courant de la vessie causé par les blessures médullaires et d'autres maladies neurodégénératives, telles que la sclérose en plaques ou la maladie de Parkinson.
A propos de EG 427 :
EG 427 est le leader mondial de l’utilisation des vecteurs non-réplicatifs dérivés de HSV-1 (nrHSV-1) en neurologie, avec une autorisation d’essai clinique (IND) obtenue de la Food and Drug Administration (FDA) des Etats-Unis en juin 2024. Cette étude est en cours aux Etat-Unis. Ce premier essai chez l'homme d'un tel vecteur cible les maladies des neurones sensoriels. Le produit, EG110A, est destiné au traitement de multiples maladies graves de la vessie, telles que la vessie neurogène (NDO) et la vessie hyperactive (OAB), et a le potentiel de constituer une amélioration majeure par rapport aux thérapies existantes, permettant de meilleurs soins pour les patients et des coûts moindres pour les systèmes de santé.
La plateforme de vecteurs propriétaires HERMES permet de développer des thérapies ciblées pour le traitement les maladies prévalentes du système nerveux périphérique et central. Ces vecteurs peuvent réaliser une transduction focale dans des régions spécifiques, puis une expression sélective des transgènes dans des sous-ensembles ciblés de neurones grâce au contrôle d'éléments de régulation sophistiqués. Avec une sécurité clinique démontrée et la possibilité d'administrer des doses répétées, la charge utile génomique des vecteurs nrHSV-1 permet une délivrance polyvalente d’ADN thérapeutique pour une médecine génomique plus efficiente.
Source : Communiqué de presse
Les fonds levés permettront de financer l’étude de phase 1b/2a de EG110A, notamment l’évaluation de son profil de sécurité et des premiers résultats d'efficacité.
Cette étude ouvre la voie au développement clinique dans plusieurs indications à fort besoin médical en neuro-urologie.
Le financement soutiendra également le pipeline préclinique de la société, basé sur sa plateforme technologique propriétaire de vecteurs, HERMES.
EG 427, une société de biotechnologie leader dans le développement de médecine génomique de précision pour les maladies chroniques prévalentes en neurologie, annonce aujourd'hui la clôture d’un tour de financement de série B de 27 millions d’euros, mené conjointement par Andera Partners et Bpifrance, dans le cadre de sa stratégie d'investissement InnoBio.
« La réussite de cette levée de fonds constitue une étape décisive pour EG 427, qui bénéficie du soutien de deux investisseurs institutionnels majeurs, Andera Partners et Bpifrance, ainsi que de la participation du fonds spécialisé SCI Ventures et du soutien continu de nos investisseurs historiques. Notre approche de médecine génomique peut répondre à des besoins médicaux majeurs, touchant de larges populations de patients atteints de maladies chroniques sévères. Nous nous concentrons en premier lieu sur les pathologies en neuro-urologie, pour lesquelles il existe peu d’innovations récentes, et dont l’impact financier est majeur pour les systèmes de santé. Ce tour de table nous permet de faire progresser notre étude clinique en cours pour notre premier programme ciblant les dysfonctions de la vessie, telles que la vessie neurogène. Celle-ci fournira des données essentielles sur la sécurité du produit et potentiellement les premiers signes d’efficacité », déclare Philippe Chambon, MD, PhD, Président et Directeur Général d'EG 427.
« En tant que leader mondial dans le développement des vecteurs non-réplicatifs HSV en neurologie, EG 427 a le potentiel de faire progresser considérablement l’utilisation de la médecine génomique grâce à l’extrême précision de ces vecteurs et leur administration locale. De plus, la plateforme d'EG 427 pourrait permettre des administrations répétées et une production à des coûts plus abordables comparés aux vecteurs AAV. En cas de succès, cette approche pourrait offrir une solution thérapeutique durable aux patients souffrant de maladies neurologiques chroniques », ajoute Benoît Barteau, Directeur d'Investissement chez Bpifrance – fonds InnoBio.
« La technologie d'EG 427 a le potentiel de bouleverser profondément les modalités actuelles de traitement. Le premier programme, EG110A, pourrait considérablement améliorer les options thérapeutiques dans un large panel d'indications en neuro-urologie, actuellement insuffisamment prises en charge. Nous sommes ravis d’avoir co-mené ce tour de table pour faire avancer EG110A en clinique et soutenir le développement plus large de la plateforme de médecine génomique d’EG 427 », déclare Raphaël Wisniewski, Associé chez Andera Partners.
Les fonds levés seront utilisés pour financer le développement d’EG110A en phase 1b/2a pour le traitement de l’hyperactivité du détrusor d’origine neurogène (NDO) chez les patients atteints de blessure médullaire (SCI). Cette étude menée aux États-Unis pourrait ouvrir la voie au développement clinique dans plusieurs indications à fort besoin médical en neuro-urologie, qui affectent des millions de patients.
Ce financement soutiendra également le développement du pipeline d’EG 427 constitué de plusieurs vecteurs thérapeutiques basés sur sa technologie exclusive HERpes Modular Expression System (HERMES). Dans les maladies ciblées, cette technologie offre la capacité de maintenir une activité à long terme et d'assurer un coût de production réduit, apportant ainsi un bénéfice médical et économique significatif aux systèmes de santé.
MTS Health Partners a été le conseil financier exclusif d'EG 427 lors de ce tour de table.
A propos de EG110A :
EG110A est une thérapie génique utilisant un vecteur HSV-1 non réplicatif, qui a été conçue pour inhiber de manière sélective l’activité des principaux neurones sensoriels de la vessie qui sont responsables de l'hyperactivité du muscle vésical, tout en préservant la fonction de miction. L'hyperactivité vésicale neurogène est un dysfonctionnement courant de la vessie causé par les blessures médullaires et d'autres maladies neurodégénératives, telles que la sclérose en plaques ou la maladie de Parkinson.
A propos de EG 427 :
EG 427 est le leader mondial de l’utilisation des vecteurs non-réplicatifs dérivés de HSV-1 (nrHSV-1) en neurologie, avec une autorisation d’essai clinique (IND) obtenue de la Food and Drug Administration (FDA) des Etats-Unis en juin 2024. Cette étude est en cours aux Etat-Unis. Ce premier essai chez l'homme d'un tel vecteur cible les maladies des neurones sensoriels. Le produit, EG110A, est destiné au traitement de multiples maladies graves de la vessie, telles que la vessie neurogène (NDO) et la vessie hyperactive (OAB), et a le potentiel de constituer une amélioration majeure par rapport aux thérapies existantes, permettant de meilleurs soins pour les patients et des coûts moindres pour les systèmes de santé.
La plateforme de vecteurs propriétaires HERMES permet de développer des thérapies ciblées pour le traitement les maladies prévalentes du système nerveux périphérique et central. Ces vecteurs peuvent réaliser une transduction focale dans des régions spécifiques, puis une expression sélective des transgènes dans des sous-ensembles ciblés de neurones grâce au contrôle d'éléments de régulation sophistiqués. Avec une sécurité clinique démontrée et la possibilité d'administrer des doses répétées, la charge utile génomique des vecteurs nrHSV-1 permet une délivrance polyvalente d’ADN thérapeutique pour une médecine génomique plus efficiente.
Source : Communiqué de presse
Les investisseurs et experts de l'opération
| Investisseur | |
| ANDERA PARTNERS (53) | |
| BPI FRANCE INVESTISSEMENT (824) |
Toute l'actualité de
| Trouver des sociétés à reprendre dans le secteur "Biotechnologie" |
|---|
| Laboratoire de tests
CA : 700 k€
Réf. : V80691
Posté le 22/11/2024Nord-Pas-de-Calais, France |
| Fabricant et distributeur de principes actifs naturels pour la santé, l'agriculture et la cosmétique
CA : 560 k€
Réf. : V68817
Posté le 09/03/2026Drôme |
| Tests rapides Adn de diagnostic des parasites des cultures
CA : 50 k€
Réf. : V80695
Posté le 25/11/2024Essonne |
| Formule d'un produit cicatrisant pour animaux
CA : 0 k€
Réf. : V78660
Posté le 28/12/2024France |
| Recherche et développement de nanomédicaments
CA : 0 k€
Réf. : V82042
Posté le 13/02/2025Isère |
| Les sociétés à reprendre du secteur "Biotechnologie" / en Ile-de-France |
| Ils veulent faire des acquisitions dans le secteur "Biotechnologie" |
|---|
| Dispositif médical ou compléments alimentaires naturels
CA Max : 20 000 k€
Réf. : A17189
Bretagne, France |
| Produits et / ou services dans le médical
CA Max : 7 000 k€
Réf. : A11145
France |
| Les acheteurs du secteur "Biotechnologie" |